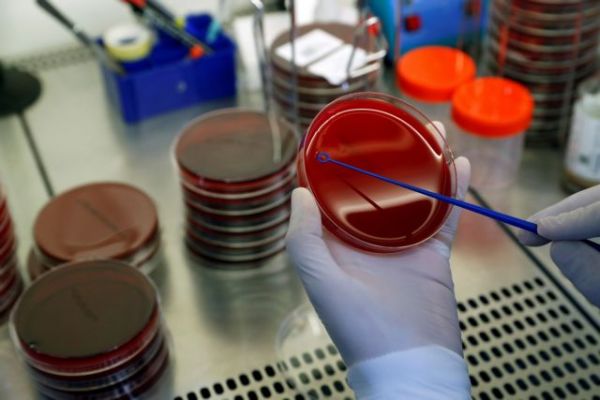
Κοροναϊός: Τα ενθαρρυντικά νέα Μαγιορκίνη για το εμβόλιο

Αυξημένος ο κίνδυνος πρόωρου θανάτου για γυναίκες με ακανόνιστους και μακρούς κύκλους περιόδου
Οι γυναίκες που έχουν ακανόνιστους και μακρούς κύκλους εμμηνόρροιας (περιόδου) αντιμετωπίζουν αυξημένο κίνδυνο πρόωρου θανάτου πριν από τα 70 τους, σύμφωνα με μια νέα αμερικανική επιστημονική μελέτη

Αριθμός Πιστοποίησης Μ.Η.Τ.232442
Αριθμός Πιστοποίησης Μ.Η.Τ.232442